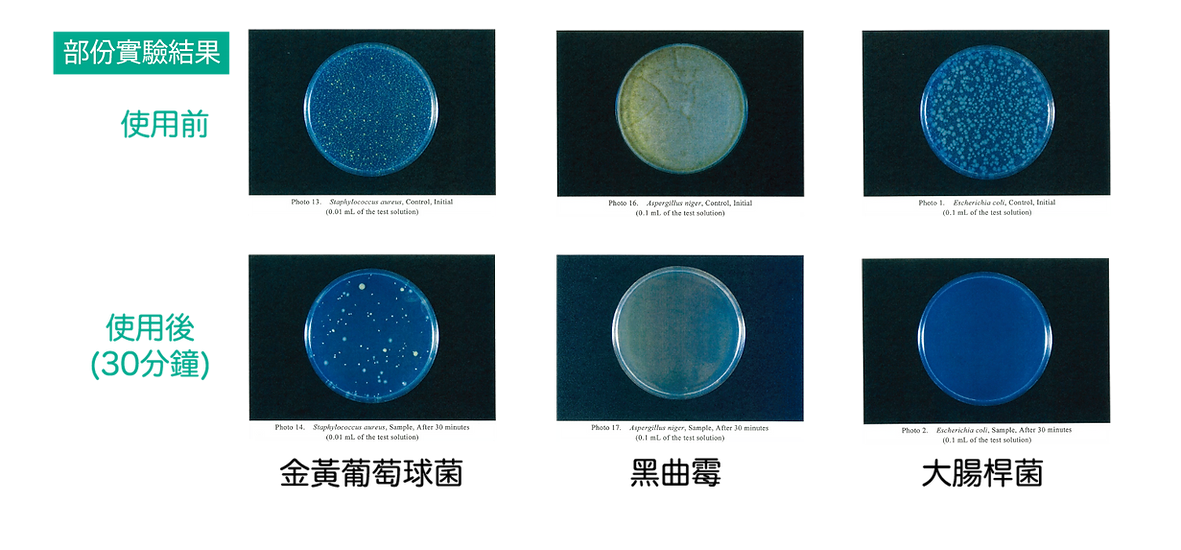

{{ 'fb_in_app_browser_popup.desc' | translate }} {{ 'fb_in_app_browser_popup.copy_link' | translate }}
{{ 'in_app_browser_popup.desc' | translate }}
{{ childProduct.title_translations | translateModel }}
{{ getChildVariationShorthand(childProduct.child_variation) }}
{{ getSelectedItemDetail(selectedChildProduct, item).childProductName }} x {{ selectedChildProduct.quantity || 1 }}
{{ getSelectedItemDetail(selectedChildProduct, item).childVariationName }}
商品編號:000237
由118種植物精華提煉而成
經JFRL日本食品分析研究所認證的專利配方
可分解、去除頑固臭味
純植物精華,對主人和寵物100%安全無害
無刺激性、無腐蝕性
需稀釋100-200倍使用
適用在獸醫診所、寵物店、寄養中心、家居使用
全店,購物滿 $400,免費送貨。
商品存貨不足,未能加入購物車
您所填寫的商品數量超過庫存
{{'products.quick_cart.out_of_number_hint'| translate}}
{{'product.preorder_limit.hint'| translate}}
每筆訂單限購 -1 件
{{'products.quick_cart.quantity_of_stock_hint'| translate : {message: quantityOfStock} }}